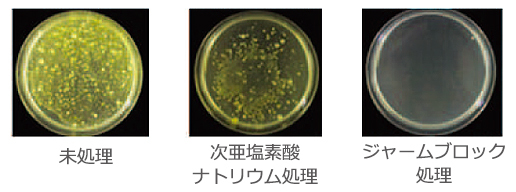

ジャームブロックの効果・使い方・注意点など
ジャームブロックの効果・
使い方・注意点など


【 弱酸性次亜塩素酸水という除菌剤 】
人体と環境にやさしい

シャンプーなどにも使われる弱酸性の性質を持ったジャームブロックは、有機物に触れると水に戻るため肌に優しく、下水に流しても環境への悪影響はありません。
岡山大学との共同開発により、安全性試験を行い、各種試験でいずれも安全性を確認済みです。
・ラットを用いた経口投与試験 ・ラットを用いた噴霧吸入試験 ・ラットを用いた皮膚刺激性試験 ・ラットを用いた眼刺激試験(岡山大学医学部附属動物実験施設調べ)
弱酸性次亜塩素酸水ジャームブロックは不燃性なので安心

除菌・消臭には弱酸性が一番

有効塩素と次亜塩素が融合したジャームブロックは、アルカリ性ではありません。除菌力・消臭力に最も効果を発揮する「弱酸性」の性質を持っています。

効果・実験データ

有効塩素と次亜塩素酸が融合したジャームブロックは、除菌力・消臭力に最も効果を発揮する「弱酸性」の性質を持っています。
◆弱酸性の力
1:弱酸性次亜塩素酸水は、インフルエンザウィルスを不活性化します
A香港型インフルエンザウィルス(H3)に弱酸性次亜塩素酸水(pH6.2)を作用させた結果、液相においては、有効塩素濃度 2ppm、接触時間1分間という非常に低濃度、短時間で十分な効果を示した。(表1)
インフルエンザウィルスを空気中(円筒型試験槽)に噴霧し、さらに弱酸性次亜塩素酸水または蒸留水を噴霧した。ウィルスのみを噴霧した場合と比較し、弱酸性次亜塩素酸水を噴霧した場合のウィルス感染力価は1/1000以上減少した。(図1)

奥邨大輔(北海道大学)、伊木重雄(北海道立衛生研究所)等
平成19年度空気調和・衛生工学会大会発表(仙台)

小宮山寛機(北里研究所)
第1回微酸性電解水研究会講演集P7

弱酸性次亜塩素酸水
という除菌剤
人体と環境にやさしい

シャンプーなどにも使われる弱酸性の性質を持ったジャームブロックは、有機物に触れると水に戻るため肌に優しく、下水に流しても環境への悪影響はありません。
岡山大学との共同開発により、安全性試験を行い、各種試験でいずれも安全性を確認済みです。
・ラットを用いた経口投与試験 ・ラットを用いた噴霧吸入試験 ・ラットを用いた皮膚刺激性試験 ・ラットを用いた眼刺激試験(岡山大学医学部附属動物実験施設調べ)
弱酸性次亜塩素酸水
ジャームブロックは
不燃性なので安心

除菌・消臭には弱酸性が一番

有効塩素と次亜塩素が融合したジャームブロックは、アルカリ性ではありません。除菌力・消臭力に最も効果を発揮する「弱酸性」の性質を持っています。

効果・実験データ

有効塩素と次亜塩素酸が融合したジャームブロックは、除菌力・消臭力に最も効果を発揮する「弱酸性」の性質を持っています。
◆弱酸性の力
1:弱酸性次亜塩素酸水は、インフルエンザウィルスを不活性化します
A香港型インフルエンザウィルス(H3)に弱酸性次亜塩素酸水(pH6.2)を作用させた結果、液相においては、有効塩素濃度 2ppm、接触時間1分間という非常に低濃度、短時間で十分な効果を示した。(表1)
インフルエンザウィルスを空気中(円筒型試験槽)に噴霧し、さらに弱酸性次亜塩素酸水または蒸留水を噴霧した。ウィルスのみを噴霧した場合と比較し、弱酸性次亜塩素酸水を噴霧した場合のウィルス感染力価は1/1000以上減少した。(図1)

奥邨大輔(北海道大学)、伊木重雄(北海道立衛生研究所)等
平成19年度空気調和・衛生工学会大会発表(仙台)

小宮山寛機(北里研究所)
第1回微酸性電解水研究会講演集P7

